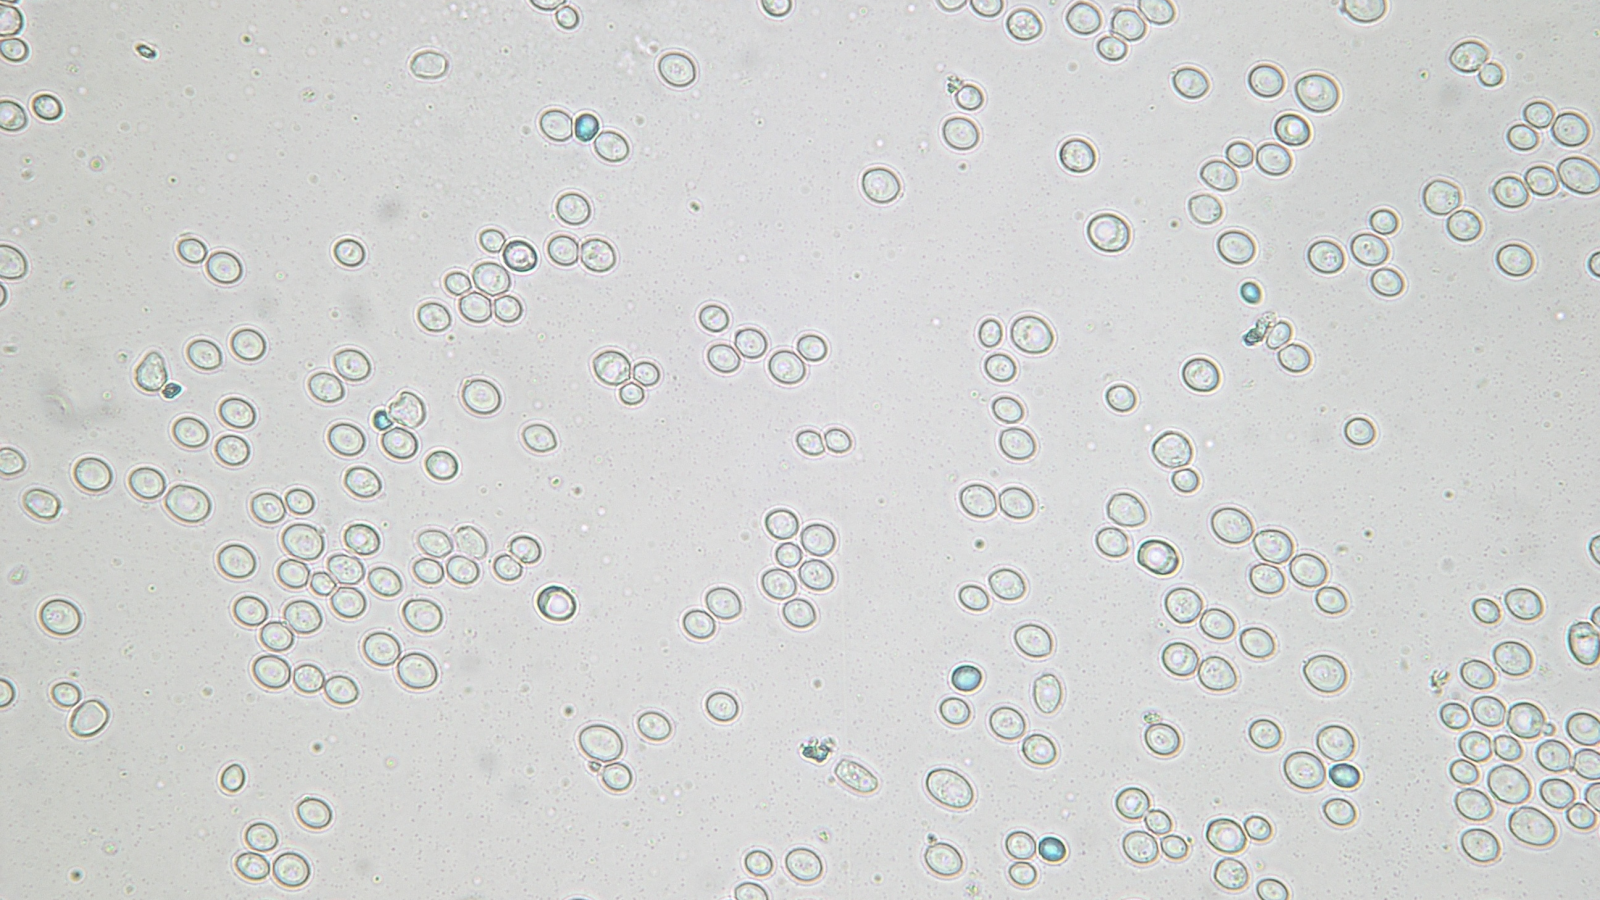
Budějovický Budvar – Výdej kvasnic

Události
O nás
Slogan
Zadejte množství a termín, kdy si chcete kvasnice vyzvednout. Po
Kdo jsme
Zadejte množství a termín, kdy si chcete kvasnice vyzvednout. Po potvrzení rezervace budou připravené.
Souřadnice místa odběru: 48.995768, 14.476626
–––
Pravidla pro výdej kvasnic externím odběratelům:
1. Výdejní dny jsou úterý a středa v čase 7 až 13 hodin, středisko CKT.
2. Vydává se do vlastních nádob odběratelů.
3. První odběr je zdarma, poté 60 Kč bez DPH za litr kvasnic.
4. Splatnost faktur 14 dní.
5. K fakturaci je potřeba:
- název a adresa pivovaru (odběratele),
- IČO
- číslo účtu z kterého bude prováděna platba,
- e-mail, na který se budou zasílat faktury.
Adresa
Souřadnice: 48.995770, 14.476619, České Budějovice
Otevírací doba
pondělí
Zavřeno
úterý
07:00 – 13:00
středa
07:00 – 13:00
čtvrtek
Zavřeno
pátek
Zavřeno
sobota
Zavřeno
neděle
Zavřeno